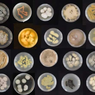
Mahasiswa S-1 di Hawaii Temukan Jamur Pemakan Plastik

Penulis

KOMPAS.com - Sebanyak 50 daftar situs warisan dunia UNESCO terancam rusak parah akibat perubahan iklim.
Dari 50 situs tersebut, tiga di antaranya ada di Indonesia. Temuan tersebut mengemuka berdasarkan analisis yang dilakukan Climate X.
Ketiga situs warisan dunia di Indonesia yang terancan hilang akibat perubahan iklim yaitu sistem pertanian Subak di Bali, Tambang Batu Bara Ombilin di Sumatera Barat, dan Taman Nasional Komodo di Nusa Tenggara Timur (NTT).
Baca juga: Perubahan Iklim Bikin Konstruksi Rentan Rusak, Pustral UGM Usulkan Jalan Ramah Lingkungan
Tiga situs tersebut terancam akibat dampak ekstrem dari perubahan iklim seperti banjir, kenaikan permukaan air laut, suhu panas ekstrem, dan risiko kekeringan.
Dalam penelitannya, Climate X melakukan permodelan terhadap 500 situs warisan dunia UNESCO apabila perubahan iklim terus berlangsung.
Hasil permodelan menunjukkan, 50 situs warisan dunia menghadapi ancaman serius kejadian ekstrem akibat perubahan iklim.
Bahkan, situs-situ tersebut rawan mengalami kerusakan yang parah pada 2050 alias 35 tahun lagi bila emisi gas rumah kaca (GRK) tak segera ditekan.
Baca juga: Berapa Banyak Spesies yang Akan Punah akibat Perubahan Iklim?
CEO sekaligus salah satu pendiri Climate X Lukky Ahmed menekankan implikasi mendalam dari temuan ini.
Ahmed menuturkan, situs-situs warisan dunia tersebut berusia ribuan tahun dan merupakan sejarah peradaban manusia.
"Dampak potensial perubahan iklim pada situs-situs ini sangat besar. Bukan hanya warisan masa lalu kita yang terancam, tetapi juga masa kini kita," kata Ahmed sebagaimana dilansir The Ethos, November 2024.
Dia menyampaikan, selain mengancam masa lalu dan masa depan manusia, perubahan iklim juga memiliki dampak sosial dan ekonomi dunia saat ini.
Baca juga: Laju Pemanasan Laut Melonjak, Tanda Perubahan Iklim Makin Cepat
"Temuan kami menjadi peringatan keras bagi pemerintah, pelestari lingkungan, dan masyarakat global untuk memprioritaskan perlindungan planet kita untuk melestarikan monumen kuno dan aset serta infrastruktur kita saat ini. Dan untuk melindungi kehidupan saat ini dan di masa depan," tutur Ahmed.
Climate X didirikan pada 2020 dan berada di garis depan dalam menganalisis risiko iklim.
Perusahaan yang berbasis di London, Inggris, tersebut memanfaatkan data yang tersedia untuk membuat permodelan dampak iklim ke sejumlah sektor seperti perbankan, real estat, dan infrastruktur.
Teknologi ini memungkinkan para pemangku kepentingan untuk membuat keputusan yang tepat guna mengurangi potensi kerusakan dan melestarikan aset bersejarah sekaligus aset kontemporer.
Baca juga: Trump Tarik AS dari Perjanjian Paris, Perlawanan Perubahan Iklim Hadapi Pukulan Besar
Mari berkontribusi langsung dalam upaya mencegah dan mengatasi masalah STUNTING di Indonesia. Ikut berdonasi dengan klik Kompas.com Jernih Berbagi.Artikel ini merupakan bagian dari Lestari KG Media, sebuah inisiatif untuk akselerasi Tujuan Pembangunan Berkelanjutan. Selengkapnya